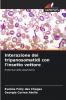
Interazione dei tripanosomatidi con l'insetto vettore

Paperback
₹3943
(All inclusive*)
Delivery Options
Please enter pincode to check delivery time.
*COD & Shipping Charges may apply on certain items.
Review final details at checkout.
Looking to place a bulk order? SUBMIT DETAILS
About The Book
Description
Author(s)
Nel continente americano due specie di tripanosomi hanno una grande incidenza e importanza medica il Trypanosoma cruzi e il Trypanosoma rangeli. Questi due parassiti utilizzano ospiti invertebrati membri della famiglia Reduviidae in particolare il Rhodnius prolixus. Durante il suo ciclo vitale il T. rangeli attraversa l'epitelio intestinale e invade l'emolinfa dell'insetto mentre il T. cruzi rimane nel lume dell'intestino del vettore. Nel presente studio abbiamo dimostrato per la prima volta l'assorbimento della lipoforina (Lp) che è la principale particella di trasporto dei lipidi nell'emolinfa dell'insetto da parte di questi tripaossomi.
Delivery Options
Please enter pincode to check delivery time.
*COD & Shipping Charges may apply on certain items.
Review final details at checkout.
Details
ISBN 13
9786202370387
Publication Date
-11-08-2025
Pages
-80
Weight
-122 grams
Dimensions
-152x229x4.87 mm